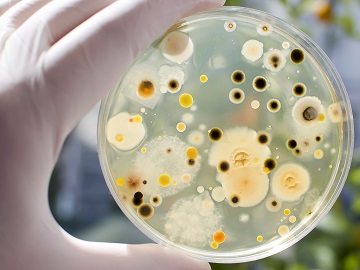

Animal By-Product Testing
Contact usWe can assist you with your carcass swab testing. Testing follows the requirements in the Meat Industry Guide and Regulation (EC) No. 2073/2005 on microbiological criteria for foodstuffs.
Our laboratory offers a full suite of animal feed testing services to support regulatory compliance and ensure the quality of your feed products.
Microbiological testing
Our laboratory is equipped to conduct all required microbiological analyses, including Salmonella and Enterobacteriaceae testing, ensuring your feed is safe and compliant with ABPR requirements.
Nutritional analysis
Assess the nutritional profile of your animal feed with our in-house analysis of:
-
Moisture
-
Oil
-
Protein
-
Fibre
-
Ash
Mineral, contaminant, and rancidity testing
Our Chemistry department offers a range of tests to analyse minerals, detect contaminants, and assess rancidity, helping you maintain feed quality and safety standards. Many of these tests are covered under our accredited scopes, ensuring reliability and accuracy.
Tailored testing solutions
We understand that every client has unique requirements, and our services are designed to be flexible and responsive. We provide tailored advice on sampling techniques, comprehensive result interpretation, and a bespoke approach to testing to meet your specific needs. Our Microbiology Departments are also equipped to offer an onsite service, delivering convenient and efficient testing solutions directly at your location.
Contact us today to learn more about our accredited animal feed testing services and how we can help you ensure the safety, compliance, and quality of your feed products.
Microbiology
We offer a range of services for the Anaerobic Digestate and Biogas Industry which also includes the PAS110 testing of Salmonella and E.coli.
We work in conjunction with Eurofins Agro Testing UK to provide a range of services including inhibition testing as part of our feed stock analysis, PAS100 and PAS110 analysis.
Find out more about our compost and digestate testing.
Chemistry
We work in conjunction with Eurofins Agro UK Ltd to offer a range of services.
The Publicly Available Specification 100 (BSI PAS 100) for composted materials developed by the Association for Organics Recycling (AFOR) is the minimum specification that composted materials must meet. It is a way of evaluating the safety, reliability and consistency of compost. This is required in order to achieve the independently verified Compost Certification Scheme.
Additionally, Eurofins network of companies offers accredited testing for Government-backed schemes such as the Feed Materials Assurance Scheme; ensuring animal feed stuffs are contaminant-free, and PAS 100, ensuring the safety of composted materials.
Eurofins companies can also offer
| Accredited non ABPR chemistry and microbiology testing on pet food | Meat Species Testing via qualitative or semi-quantitative tests on the basis of Real-Time PCR and DNA sequencing as well as ELISA |
| Vitamin and amino acid analysis | Testing to FEDIAF guidelines |